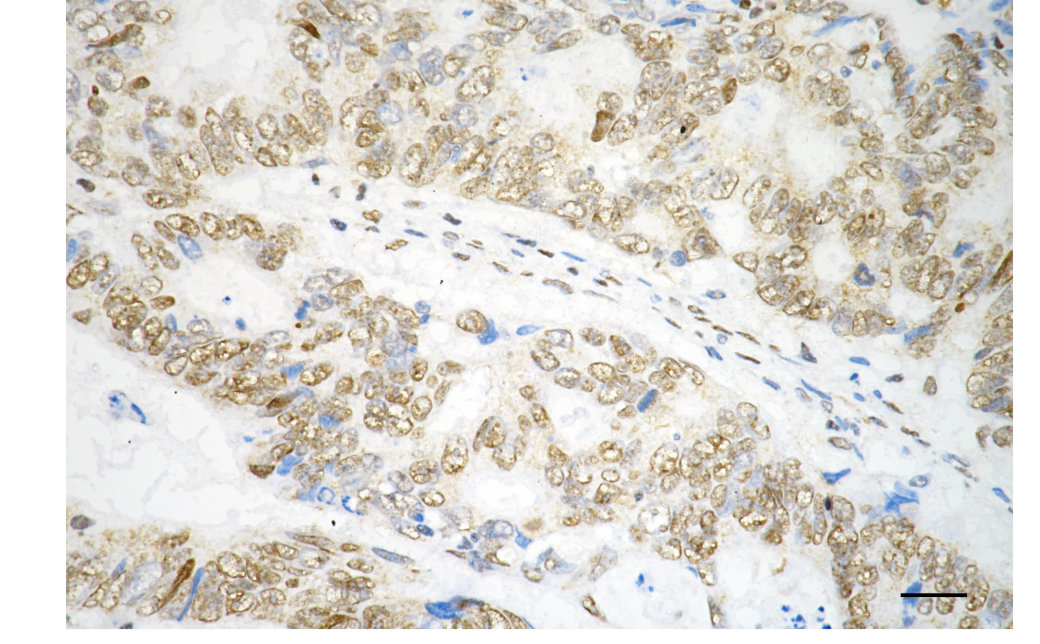

PTBP1 Recombinant Monoclonal Antibody
-
中文名稱:PTBP1 Recombinant Monoclonal Antibody
-
貨號:CSB-RA182596A0HU
-
規格:¥1320
-
圖片:
-
Flow cytometric analysis of PTBP1 expression in HAP-1 cells using PTBP1 antibody. Green, isotype control; red, PTBP1.
-
Immunocytochemical staining of HAP1 cells with PTBP1 antibody. Nuclei were stained blue with DAPI; PTBP1 was stained magenta with Alexa Fluor? 647. Images were taken using Leica stellaris 5. Protein abundance based on laser Intensity and smart gain: Medium. Scale bar, 20 μm.
-
Immunohistochemistry was performed on paraffin-embedded human sigmoid colon carcinoma using PTBP1 antibody. Antigen retrieval was done in sodium citrate buffer (pH 6.0). DAB was used for detection, with hematoxylin counterstaining. Images were acquired using a Nikon Ci-L Plus microscope (40× objective). Scale bar: 25 μm.
-
Immunohistochemistry was performed on paraffin-embedded mouse liver using PTBP1 antibody. Antigen retrieval was done in sodium citrate buffer (pH 6.0). DAB was used for detection, with hematoxylin counterstaining. Images were acquired using a Nikon Ci-L Plus microscope (40× objective). Scale bar: 25 μm.
-
Immunohistochemistry was performed on paraffin-embedded mouse kidney using PTBP1 antibody. Antigen retrieval was done in sodium citrate buffer (pH 6.0). DAB was used for detection, with hematoxylin counterstaining. Images were acquired using a Nikon Ci-L Plus microscope (40× objective). Scale bar: 25 μm.
-
Immunohistochemistry was performed on paraffin-embedded mouse brain using PTBP1 antibody. Antigen retrieval was done in sodium citrate buffer (pH 6.0). DAB was used for detection, with hematoxylin counterstaining. Images were acquired using a Nikon Ci-L Plus microscope (40× objective). Scale bar: 25 μm.
-
Western blotting analysis using PTBP1 antibody. Total cell lysates (30 μg) from various cell lines were loaded and separated by SDS-PAGE. The blot was incubated with PTBP1 antibody and HRP-conjugated goat anti-rabbit secondary antibody respectively.
-
-
其他:
產品詳情
-
Uniprot No.:
-
基因名:PTBP1
-
別名:Polypyrimidine Tract Binding Protein 1; Heterogeneous Nuclear Ribonucleoprotein I; HNRNP-I; HNRPI; PTB-1; PTB2; PTB3; PTB4; PPTB; PTB; Polypyrimidine Tract Binding Protein (Heterogeneous Nuclear Ribonucleoprotein I); Polypyrimidine Tract-Binding Protein 1; 57 KDa RNA-Binding Protein PPTB-1; HnRNP I; Heterogeneous Nuclear Ribonucleoprotein Polypeptide I; RNA-Binding Protein; HNRNPI; PTB-T
-
反應種屬:Human, Mouse, Rat
-
免疫原:Recombinant Human PTBP1 protein
-
免疫原種屬:Homo sapiens (Human)
-
標記方式:Non-conjugated
-
克隆類型:Monoclonal
-
抗體亞型:Rabbit IgG
-
純化方式:Affinity-chromatography
-
克隆號:11H4
-
濃度:It differs from different batches. Please contact us to confirm it.
-
保存緩沖液:Rabbit IgG in PBS (pH 7.4) containing 50% glycerol, and 0.02% sodium azide.
-
產品提供形式:Liquid
-
應用范圍:ELISA, WB, FC, ICC, IHC
-
推薦稀釋比:
Application Recommended Dilution WB 1:1000-1:5000 FC 1:200-1:2000 ICC 1:100-1:1000 IHC 1:100-1:200 -
Protocols:
-
儲存條件:Upon receipt, store at -20°C or -80°C. Avoid repeated freeze.
-
貨期:Basically, we can dispatch the products out in 1-3 working days after receiving your orders. Delivery time maybe differs from different purchasing way or location, please kindly consult your local distributors for specific delivery time.
-
用途:For Research Use Only. Not for use in diagnostic or therapeutic procedures.
相關產品
靶點詳情
-
功能:Plays a role in pre-mRNA splicing and in the regulation of alternative splicing events. Activates exon skipping of its own pre-mRNA during muscle cell differentiation. Binds to the polypyrimidine tract of introns. May promote RNA looping when bound to two separate polypyrimidine tracts in the same pre-mRNA. May promote the binding of U2 snRNP to pre-mRNA. Cooperates with RAVER1 to modulate switching between mutually exclusive exons during maturation of the TPM1 pre-mRNA. Represses the splicing of MAPT/Tau exon 10. In case of infection by picornaviruses, binds to the viral internal ribosome entry site (IRES) and stimulates the IRES-mediated translation.
-
基因功能參考文獻:
- experimental analysis of specimens from 3 different brain tumor groups and 1 reactive gliosis group indicates the feasibility of using anti-PTBP1 antibody in diagnostic neuropathology, and computerized image analysis provides a systematic and quantitative approach to explore feasibility PMID: 28024117
- study provides evidence for the role of PTB in keloid pathophysiology and offers a novel therapeutic target for keloids. Most importantly, the role TGF-beta1 regulation of PTB may provide new insights into the mechanisms underlying inflammatory cytokine-induced fibrosis. PMID: 27897224
- the study revealed that PTBP1 facilitates colorectal cancer migration and invasion activities by inclusion of cortactin exon 11 PMID: 28404950
- Results showed the expression level of PTBP1 were increased in bladder cancer (BC) patients and that its expression is negatively regulated by MIR-145. PMID: 28380435
- PTBP1 is a novel regulator of MCL1 mRNA by which it controls apoptotic response to antitubulin chemotherapeutics. PMID: 27367564
- PTB interacts specifically with 3'UTR of p53 mRNA and positively regulates expression of p53 isoforms. PTB showed some overlapping binding regions in the p53 3'UTR with miR-1285. Knockdown of miR-1285 as well as expression of p53 3'UTR with mutated miR-1285 binding sites resulted in enhanced association of PTB with the 3'UTR, which provides mechanistic insights of this interplay. PMID: 28973454
- It has been established that PTBP1 and PTBP2 are members of a family of cryptic exon repressors. PMID: 27681424
- These results demonstrate that during early stages of splicing, exon RNP complexes are highly dynamic with many proteins failing to bind during PTBP1 arrest. PMID: 27882870
- Studied interactions of polypyrimidine tract-binding protein (PTBP1), pyruvate kinase M2 (PKM2), and STAT3 (signal transducer and activator of transcription 3) in oncogenesis of anaplastic large cell lymphoma (ALCL). Results show that in ALCL cells, PTBP1 is crucial for PKM2 phosphorylation of STAT3 in the nucleus. PMID: 28414323
- Expression of ATG10 negatively regulated by PTBP1 and is associated with metastasis of colorectal cancer cells. PMID: 27836735
- Polypyrimidine tract binding protein (PTBP1) is a heterogeneous nuclear ribonucleoprotein (hnRNP) that plays roles in most stages of the life-cycle of pre-mRNA and mRNAs in the nucleus and cytoplasm. PMID: 27528752
- follow-up molecular analyses of one splicing factor PTBP1 revealed its impact on disease-associated splicing patterns in Huntington's disease (HD). Collectively, our data provide genomic evidence for widespread splicing dysregulation in HD brains, and suggest the role of aberrant alternative splicing in the pathogenesis of HD PMID: 27378699
- CD5 transcription is increased, leading to the production of three mRNA isoforms by APA, all contributing for protein production, at different levels. PTBP1 binds in the vicinity of pA1, leading to an increase in mRNA levels and miR-204 targets the longer CD5 mRNA. PMID: 27005442
- Increased expression of microRNA miR-145 combined with knockdown of PTBP1 protein contributed to the greater and longer growth suppression compared with each single treatment. PMID: 28106737
- MiR-133b switched the PKM isoform expression from PKM2 to PKM1 through the silencing of PTBP1, which is an alternative splicer of PKM, leading to growth suppression through the induction of autophagy in part by the metabolic switching from glycolysis to oxidative phosphorylation for a short period of time. PMID: 27696637
- Results suggested that PTBP1 and PTBP1-associated miR-1 and -133b are crucial molecules for the maintenance of the Warburg effect in colorectal tumors. PMID: 26980745
- The polypyrimidine tract binding protein 1 (PTBP1) shields specific retroviral and cellular transcripts from nonsense-mediated mRNA decay. PMID: 26744779
- findings point to PKM2 and PTBP1 as new potential therapeutic targets to improve response of PDAC to chemotherapy PMID: 26234680
- PTBP1 and PTBP2 impaired autoregulation of SRSF3 in oral squamous cell carcinoma cancer cells. PMID: 26416554
- Results suggest that the role of polypyrimidine tract binding protein 1 (PTBP1) in tumorigenesis may be partly mediated by its regulation of cdc42 GTP-binding protein (CDC42) alternative splicing and CDC42-v2 might function as a tumor suppressor. PMID: 26336992
- Data indicate that polypyrimidine tract-binding protein (PTBP1) is preferentially overexpressed in clinical colorectal cancers PMID: 25904505
- PTB/hnRNP1 binds to the 3'UTR of Human Astrovirus-8 and is required or participates in viral replication. PMID: 25406089
- Data show that the protein levels of polypyrimidine tract binding protein 1 (PTBP1) and adenosine deaminase RNA-specific binding protein ADAR1 were cooperatively expressed in glioma tissues and cells. PMID: 26047657
- Organ-specific PTB1-associated microRNAs determine expression of pyruvate kinase isoforms PMID: 25721733
- HUR competes with the host protein PTB, which is a negative regulator of hepatitis C virus replication. PMID: 26339049
- protein knockdown enhances neurogenesis PMID: 25800779
- RBFOX proteins can facilitate the splicing of micro-exons. We also found that PTBP1 likely regulates the inclusion of micro-exons, possibly by repressing the inclusion of micro-exons that are enhanced by RBFOX proteins and other splicing factors. PMID: 25524026
- ABLIM1 splicing is regulated by several splice factors, including MBNL family proteins, CELF1, 2 and 6, and PTBP1, using a cellular splicing assay. PMID: 25403273
- Suggest that miR-124 acts as a tumor-suppressor and a modulator of energy metabolism through a PTB1/PKM1/PKM2 feedback cascade in human colorectal tumor cells. PMID: 25818238
- impact of PTBP1 rs11085226 on glucose-stimulated insulin release PMID: 25927630
- IL-7 elevates miR-124 to decrease the expression of splicing regulator PTB and represses CD95 mRNA splicing. PMID: 25411246
- PTBP1 and hnRNP C repress exon 3 inclusion, and that downregulation of PTBP1 inhibited BIM-mediated apoptosis. PMID: 24743263
- Polypyrimidine tract-binding protein function is controlled by a set of co-recruited proteins and importantly provide further evidence that it is possible to dictate cell fate by modulating cytoplasmic gene expression pathways alone. PMID: 24141718
- PCBP2 and PTB are differentially cleaved by human rhinovirus proteinase in infected cells. PMID: 24418535
- PTBP1 regulates the alternative splicing of dopamine D2 receptor. PMID: 21054383
- Study reports that repression of a single RNA binding polypyrimidine-tract-binding (PTB) protein, which occurs during normal brain development via the action of miR-124, is sufficient to induce trans-differentiation of fibroblasts into functional neurons. PMID: 23313552
- conclude that common genetic variation in PTBP1 influences glucose-stimulated insulin secretion. This underlines the importance of PTBP1 for beta cell function in vivo PMID: 23077502
- Production of the USP5 isoform 2 was strongly correlated with PTBP1 expression in glioblastoma tumor samples and cell lines. PMID: 21976412
- Polypyrimidine tract binding protein (hnRNP I) is possibly a conserved modulator of miRNA-mediated gene regulation. PMID: 22427970
- PTB depletion in the dorsal telencephalon is causally involved in the development of hydrocephalus. And PTB is important for the maintenance of Adherens Junctions in the neural stem cells of the dorsal telencephalon. PMID: 22705452
- The defective splicing caused by the ISCU intron mutation in patients with myopathy with lactic acidosis is repressed by PTBP1 but can be derepressed by IGF2BP1. PMID: 22125086
- PTB is shown to bind an exonic splicing silencer element and repress alternative splicing of FADS2 PMID: 21980057
- RBM4 may synergize its effect on muscle cell-specific alternative splicing by down-regulating PTB expression and antagonizing the activity of PTB in exon selection PMID: 21518792
- Silencing the expression of PTB with small interfering RNA in two cell lines (Huh7 and HEK 293T) led to a significant increase of up to 4-fold in mRNA levels and virus titer, indicating a negative effect of PTB on coronavirus RNA accumulation. PMID: 21411518
- U1 snRNA directly interacts with polypyrimidine tract-binding protein during splicing repression PMID: 21362553
- Differentially modified PTB regulates CD40L expression at multiple steps by retaining CD40L mRNA in the nucleus, directly regulating mRNA stability at late times of activation, and forming a ribonuclear complex. PMID: 21242519
- The combined results suggest that 3C-mediated cleavage of PTB might be involved in down-regulation of viral translation to give way to subsequent viral genome replication. PMID: 19889140
- a strong correlation between the expression of PTB-1, YB-1 and c-myc in multiple myeloma-derived cell lines PMID: 20190818
- It appears that the polypyrimidine tract-binding protein might help in circularization of the coxsackievirus B3 RNA by bridging the ends necessary for efficient translation of the viral RNA. PMID: 20071487
- The slow backbone dynamics of PTB1:34, induced by packing of (RNA recognition motifs) RRM3 and RRM4, could be essential for high-affinity binding to a flexible polypyrimidine tract RNA and also provide entropic compensation for its own formation. PMID: 20080103
顯示更多
收起更多
-
亞細胞定位:Nucleus.
-
數據庫鏈接:
Most popular with customers
-
-
YWHAB Recombinant Monoclonal Antibody
Applications: ELISA, WB, IHC, IF, FC
Species Reactivity: Human, Mouse, Rat
-
Phospho-YAP1 (S127) Recombinant Monoclonal Antibody
Applications: ELISA, WB, IHC
Species Reactivity: Human
-
-
-
-
-